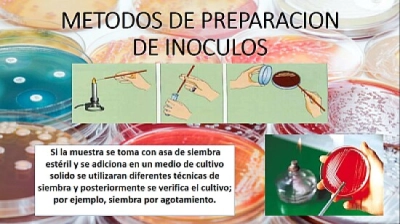

|
||||||||
|
|
||||||||
|
Il tuo tempo 00:00
|
||||||||
|
Tempo medio
00:21
|
||||||||
|
Miglior tempo
01:31
|
||||||||
 |
||||||||
|
|
||||||||
|
|||||||||||||||||||||||||||||
BIOTECNOLOGIAQuesto puzzle appartiene ad un album utente My Album Proprietario dell'album: Stephania38
Miglior punteggio di: ELetito Realizzato il: 2021-07-08 Copyright della foto: QUIMICA |
||||||
| BIOTECNOLOGIA - 25 Pezzi | |||||
| Il tuo tempo: |
|
||||
| Mostra i pezzi più grandi dietro quelli più piccoli? Sì No | |
| Condividi questo puzzle |
|
| |